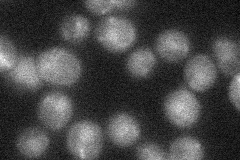

View description
Ubiquitin-like protein with similarity to mammalian NEDD8; conjugation (neddylation) substrates include the cullins Cdc53p, Rtt101p, and Cul3p; activated by Ula1p and Uba3p (E1 enzyme pair); conjugation mediated by Ubc12p (E2 enzyme)
Localization:
Intensity:
Fold change:
Significance:
-
C’ GFP library in SD

cytosol21.31 -
N' NOP1pr-GFP in SD

cytosol84.6708 -
N' TEF2pr-mCherry in SD

cytosol208.725 -
N' NATIVEpr-GFP in SD
nucleus20.0529 -
N' TEF2pr-VC and Cyto-VN in SD

#N/A0 -
C’ GFP library in SD+DTT

cytosol23.821.11No -
C’ GFP library in SD+H2O2

cytosol22.671.06No -
C’ GFP library in Starvation Media

cytosol19.170.89No -
C’ GFP library on the background of Pup2-DaMP

cytosol -
C’ GFP library on the background of CCT mutant

cytosol16.7320.785008No
